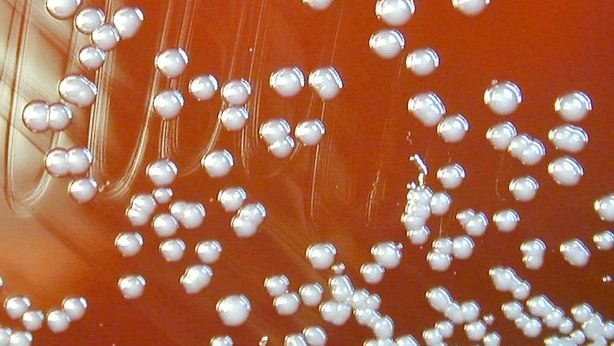
txt

كشفت وكالة الفضاء الأوروبية عن مرور مسبار «Solar Orbiter» الملقب بمسبار الشمس صباح أمس الأول، بالقرب من كوكب الزهرة.
وقال بيان صادر عن الوكالة: «مر المسبار بالقرب من كوكب الزهرة أثناء مناورة أجراها ضمن خطة رحلاته، واقترب من الكوكب لمسافة 8 آلاف كيلومتر، هذا المسبار الذي طورناه مع وكالة ناسا صمم بالأساس لدراسة الشمس، ومجهز بدرع قادرة على تحمل درجات حرارة تصل إلى 600 درجة مئوية».
وأضاف البيان: أجهزة التصوير الحرارية الموجودة على متن هذا المسبار ستساعدنا على رصد الجانب المظلم من كوكب الزهرة.
وقد أطلق المسبار في 10 فبراير2020، من مجمع الإطلاق رقم 41، بقاعدة كيب كانافيرال الفضائي بولاية فلوريدا، في رحلة تستغرق عشرة أعوام إلى الشمس.
الجدير بالذكر أن وكالة ناسا للفضاء قد أعلنت منذ أيام عن حاجتها لـ 4 أشخاص للسفر إلى المريخ لمدة عام، والخضوع أولًا إلى محاكاة تشبه الظروف المحيطة في المريخ للتكيف مع أسلوب الحياة هناك.